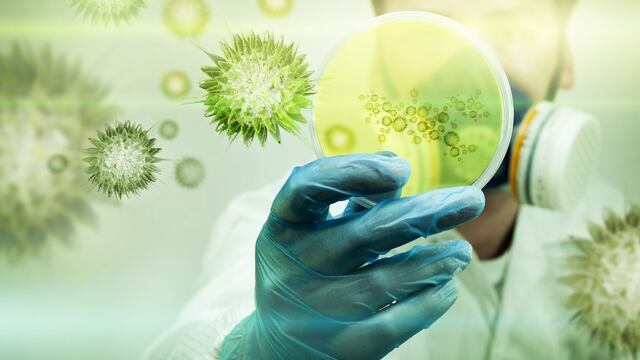

En la escuela Alfredo Bufano recibieron una réplica de la imagen de la Virgen de Luján que acompañó a los soldados argentinos en la guerra de Malvinas.
En la mañana de martes en el bachillerato de adultos que funciona en Ortubia al 2400 y fue declarado como la “Casa de los Veteranos”, se realizó una ceremonia para después entronizar la imagen junto al monumento que recuerda a los héroes argentinos que estuvieron en el conflicto del Atlántico Sur.
Tras el final de la guerra, la imagen fue llevada a Inglaterra y regresó al país a fines de 2019.
“Fue muy emotivo el acto que se realizó. Comenzó con la Santa Misa y luego hicimos una procesión para llevar a la imagen y donde va a quedar definitivamente”, contó Miguel Grillo, director de la escuela Bufano en diálogo con FM Vos (94.5).
“En el colegio tenemos un monumento a la Gesta de Malvinas, que es central, en el cual todos los días cantamos Aurora al izar la bandera y luego hacemos un responso por los caídos por la Patria en las Islas. Por eso, es tan importante contar con esta imagen. Es uno de los recuerdos que quedan par que nuestros alumnos conozcan la historia, a sus héroes, no solamente los que dejaron su sangre, sino también a aquellos que la defendieron arriesgando su propia vida”, agregó el docente.

El director comentó orgulloso que la única réplica que hay en Mendoza de la Virgen de Lujan que estuvo acompañando a los solados en el combate está en San Rafael.
“De todo Mendoza han elegido a San Rafael y esta escuela que ha sido su casa”, afirmó.
“La imagen ya puede ser visitada por el público. Recordemos que esta escuela está declarada como la Casa de los Veteranos, por ello, está abierto a la comunidad, a los que quieran venir rezar a la Virgen, conocer el monumento”, concluyó.